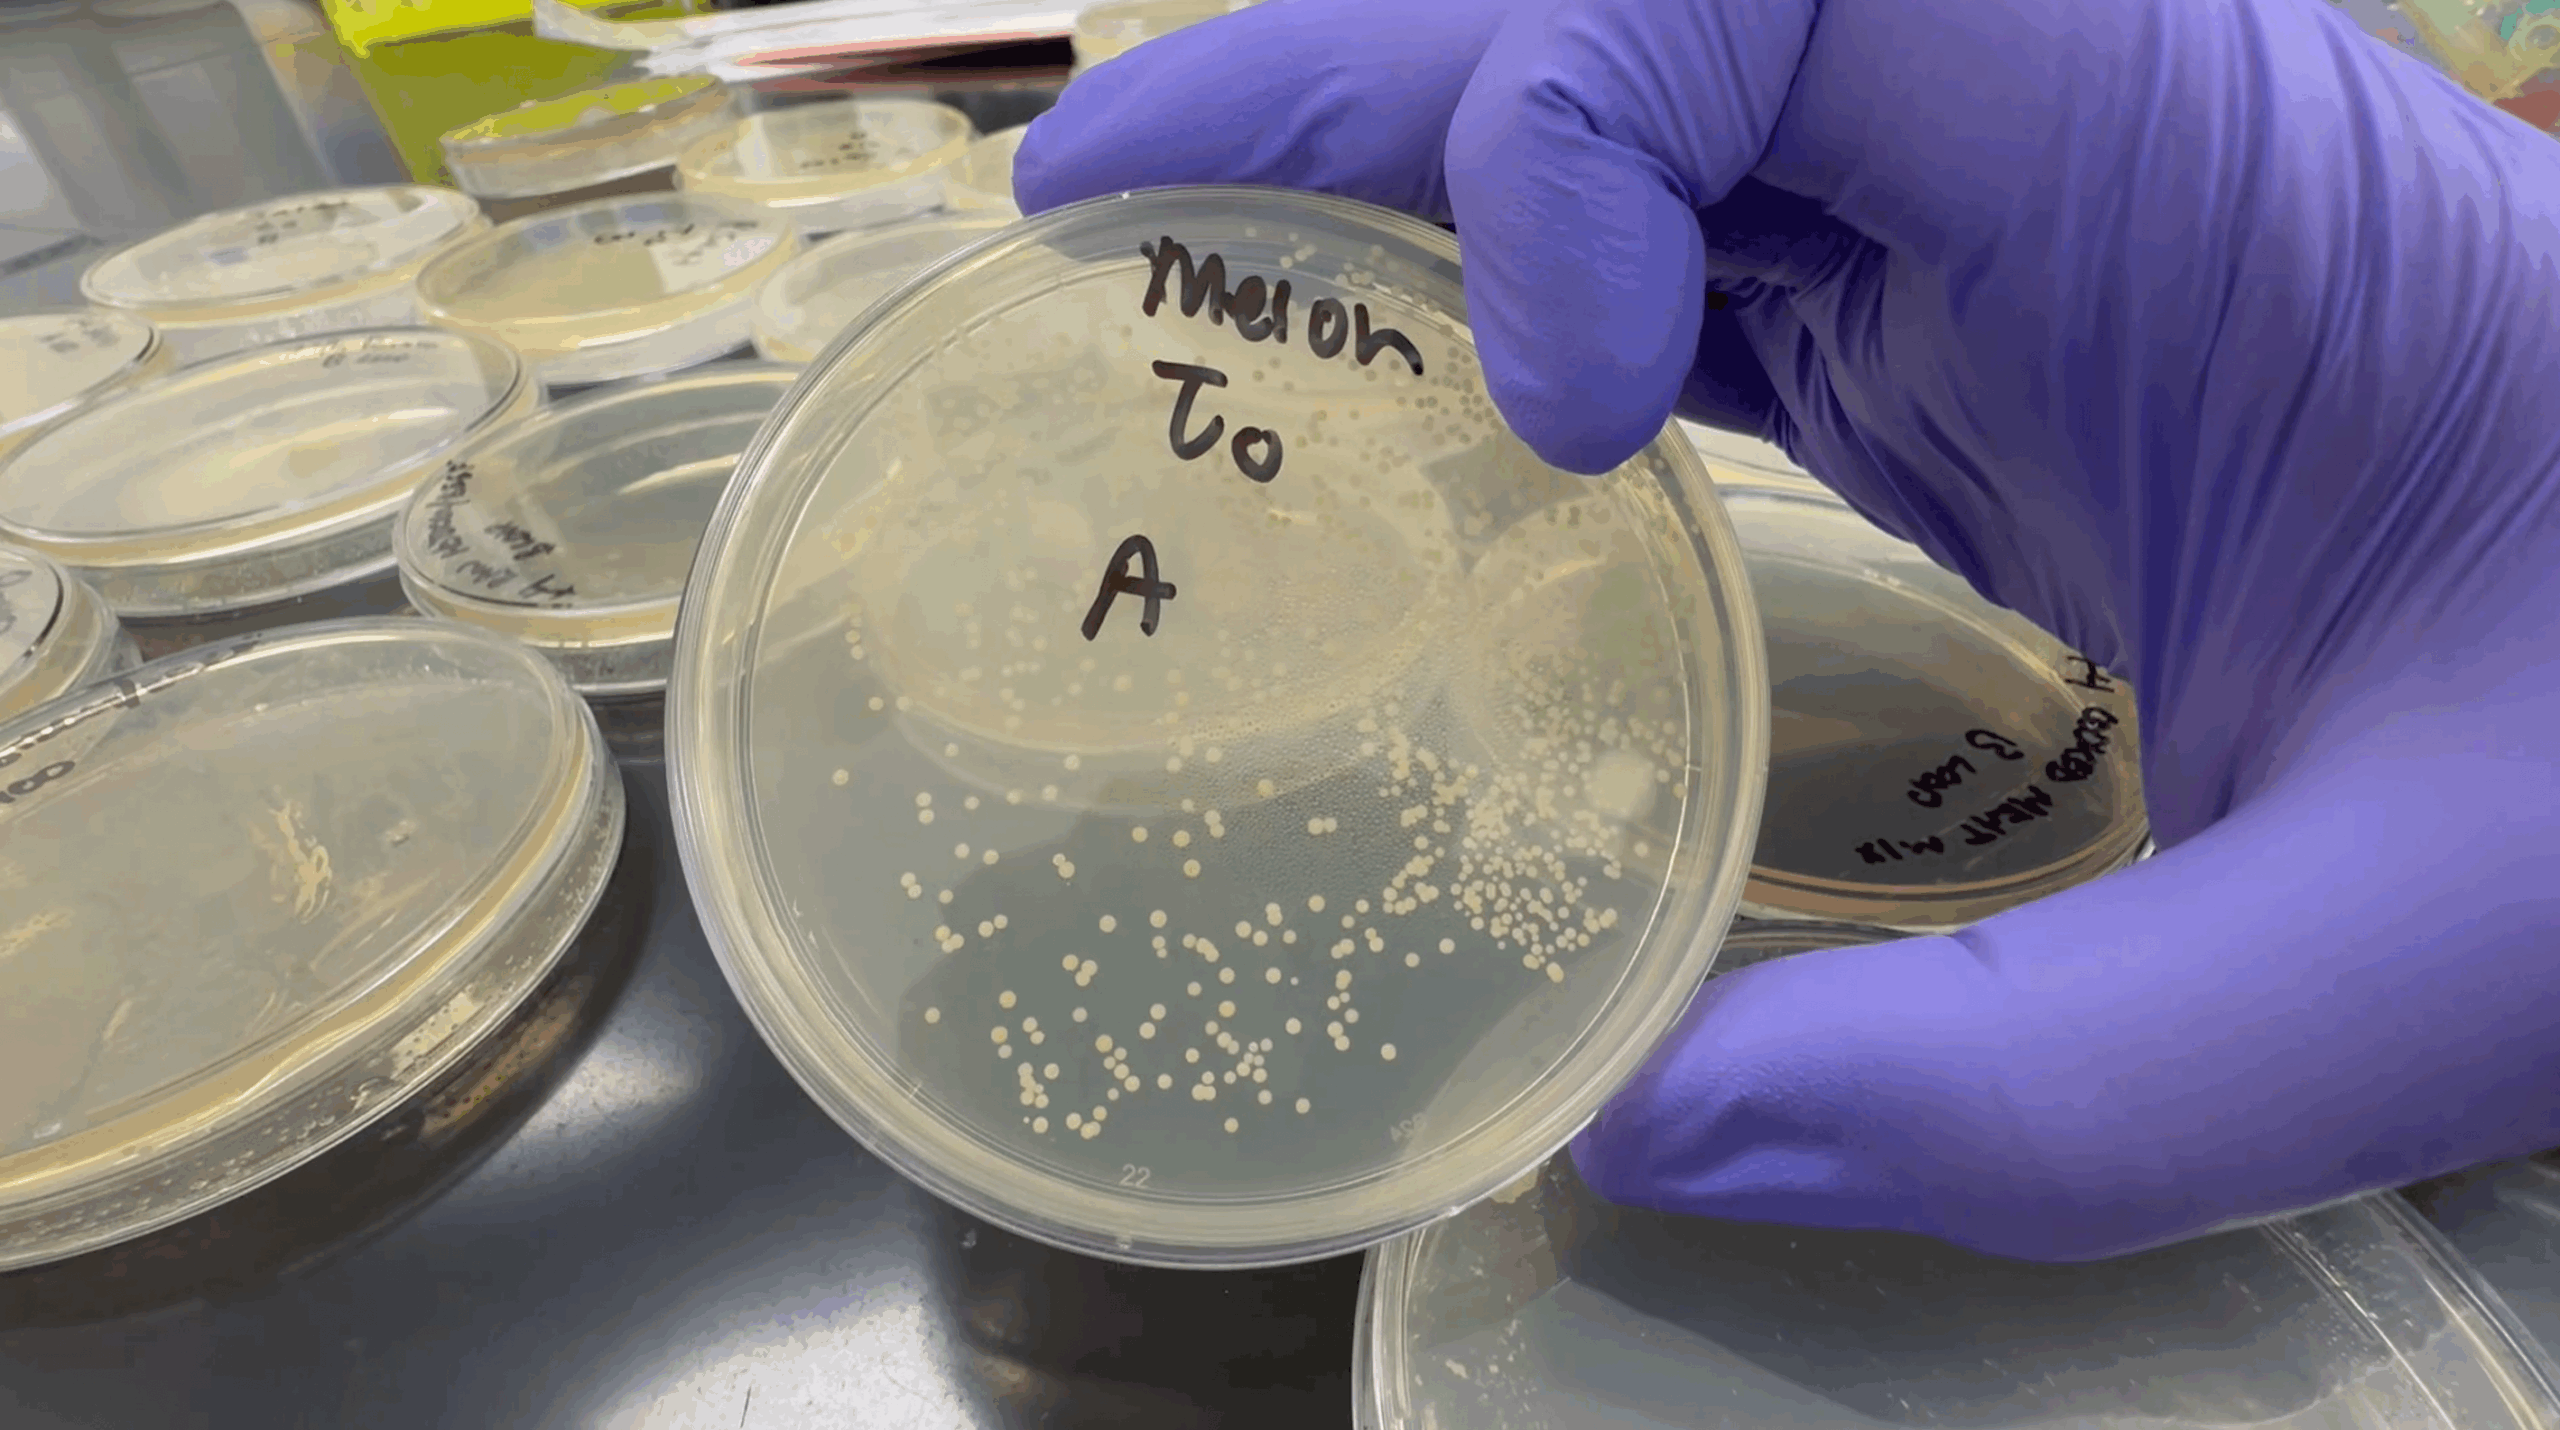

Before you claim you’re the grill master of the family, in this week’s Healthy Living Segment, UNM Health shares some helpful tips on how to avoid food poisoning.
In backyards around the country, grill masters are dusting off their aprons and firing up their barbecues. But as the summer cookout season kicks off, it’s important to remember the science behind a safe picnic.
Fortunately, the experts at The University of New Mexico College of Pharmacy have tips to keep food preppers and their loved ones out of urgent care.
Food Poisoning: What is it?
The USDA defines food poisoning as an illness that comes from eating contaminated food, and estimates there are 48 million cases and three thousand deaths from foodborne illnesses each year, in the United States.
Amer El Ghali, PharmD, an assistant professor at the UNM College of Pharmacy, said bacteria just needs the right conditions to grow.
“The perfect temperature is around 72 degrees for these bacteria to continue to propagate over time,” he said.
One of the more well-known types of bacteria that causes foodborne illness is salmonella.
“Salmonella is a big producer in food that you leave out and can produce toxins that cause irritation to the gastrointestinal lining,” El Ghali said.
Seth Daly, PhD, a research assistant professor in the UNM College of Pharmacy, said two other bacteria that often cause food poisoning are Campylobacter and E. coli.
All three culprits can cause symptoms like nausea, vomiting, diarrhea and fever.
How to Avoid Food Poisoning
Proper Preparation
Sometimes, foodborne illness can result from picking a bad vegetable at the store, but there are things you can do to avoid food poisoning at home.
It all starts with proper hygiene.
“It’s gross, but one of the major routes for bacteria transmission is the oral fecal route,” Daly said. “If someone uses the restroom and doesn’t wash their hands properly, that gets on food and can grow.”
To avoid cross contamination, you should use different cutting boards for raw meat, cooked meat, vegetables and fruit, he said.
“Putting meats on a cutting board, loading up the grill, and putting the cooked meat back on the same cutting board is a huge no-no,” Daly said. “But you can put a piece of foil down on the board for the raw chicken and remove it for the cooked chicken.”
Cautious Cooking
One of the most important things you can do to keep yourself safe from foodborne illness is cooking food to the right temperature, Daly said
“Most people don’t think to stick a meat thermometer in their food, but it can be an important thing,” he said. “It’s better to be safe than sorry.”
The CDC recommends all poultry be cooked to an internal temperature of 165 degrees Fahrenheit, whole cuts of beef, veal, lamb and pork be cooked to 145 F and ground meat, including beef and pork be cooked to 160 F.
Leftover Limbo
Just because the cooking is done, does not mean the risk of foodborne illness is gone.
“The time between food getting prepared and getting put away is critical, especially when you don’t know how it’s been handled before,” El Ghali said. “You don’t want to pass the four-hour mark. That can lead to overgrowth of bacteria to a level your immune system can’t fight.”
Both El Ghali and Daly recommend putting leftovers away after two hours and tossing anything left out after four hours.
They also said the refrigerator might fight off initial bacteria growth, but it can still grow over time if food is left long enough, and the shelf life of leftovers depends on the type of food.
“Heavily processed foods usually have a lower shelf life, but foods with higher salt contents are preserved a little bit,” El Ghali said. “Usually, one to two days on some of those processed foods is safe but just try to be as cautious as possible.”
He also said a lot of times you can use your best judgment.
“The smell test is another great thing,” El Ghali said. “If it smells off or looks funky, just toss it. It’s better than having some sort of illness.”
Proof is in the Petri Dish
Amer El Ghali, PharmD, an assistant professor at the UNM College of Pharmacy, prepares food samples in his lab. (picture above)
El Ghali is a pharmacist and researcher in infectious diseases, pharmacokinetics, pharmacodynamics, and health outcomes. His lab is researching therapeutic strategies to fight antimicrobial resistance, like combining bacteriophages with antibiotics to treat Pseudomonas aeruginosa, a multi-drug-resistant germ that causes infections in plants, animals and humans.
Daly’s lab investigates methicillin-resistant Staphylococcus aureus (MRSA), a bacterium resistant to many antibiotics. His research focuses on discovering new drugs and vaccines to combat MRSA.
So naturally, they were well equipped to try and grow bacteria from some common summer cookout foods.
Seth Daly, PhD, a research assistant professor in the UNM College of Pharmacy, swabs Petri dishes with food samples. (picture above)
Putting Food to The Test
They prepared swabs of some classic cookout staples: hot dogs, hamburgers, chicken, potato salad, watermelon and a spring mix salad.
The samples were placed in a greenhouse and left to grow bacteria for at least four hours.
Most of the samples did see growth, but just because there was growth, El Ghali said, they don’t know exactly what type of bacteria was grown and if it was harmful or not.
There are “good” bacteria that aid with digestion and overall gut health, he said. A lot of times, food poisoning wipes out the good bacteria from your gut.
A hot dog did not show much growth, and Daly said that may be because of how much the food was processed.
Potato salad also didn’t have much growth. El Ghali said the higher salt content may have contributed to the lack of growth.
Raw chicken showed the most bacteria growth from start to finish.
A slice of watermelon also had substantial growth. Daly said the sugars in the fruit, plus heat, most likely created a perfect breeding ground for growth
A tossed salad also had growth and a pigment produced by the bacteria.

An overview of different samples taken. Most had at least some growth

The raw chicken sample grew in a “lawn”. El Ghali said that means bacteria grew in a uniform way on top of itself.
The watermelon sample grew bacteria in “colonies”. El Ghali said that means bacteria grew in small clusters spread out. The white dots indicate colonies.

The spring mix salad sample grew in a “lawn” and had a color to the bacteria. The experts said this could point to a toxin grown within the bacteria. Toxins may also lead to food poisoning if enough is ingested to overwhelm your immune system.

An overview of different samples taken. Most had at least some growth

The raw chicken sample grew in a “lawn”. El Ghali said that means bacteria grew in a uniform way on top of itself.
The color shows there’s a factor that could cause a bodily response, El Ghali said. With food poisoning, it could be a toxin or molecule made by the bacterium itself that cause an illness.
Overall, in this small-scale experiment, the fresh whole foods showed more growth over the more processed and preserved foods.
Watch the video at the top of the article for more in the lab.
The bottom line? Experts advise food preppers to wash their hands and their produce. Cook meat thoroughly, get cooked food in the fridge within two hours and toss it after four hours, if it’s been sitting out.
“It can affect you and your family,” El Ghali said. “It’s very important that we are mindful of food safety regulations.”
发表回复